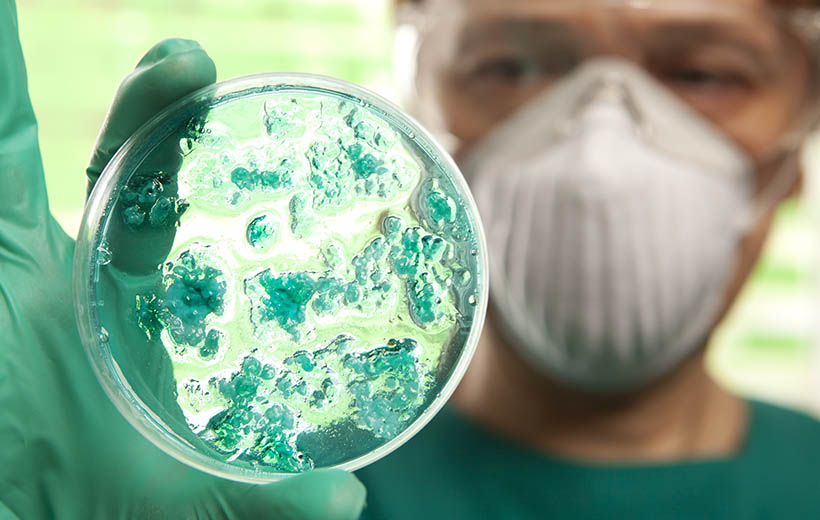
Токсокароз: симптомы и лечение у детей и взрослых

Токсокароз – паразитарное заболевание человека, вызванное личинками гельминта из группы нематод.
Болезнь имеет хроническое течение, личинки мигрируют по организму, вызывая совершенно разные проявления. Клинически возможно бессимптомное течение или тяжелое поражение внутренних органов.
Причины токсокароза
Болезнь развивается при попадании в желудочно-кишечный тракт человека яиц собачьей аскариды. Именно собачья аскарида Toxocara canis в большинстве случаев является возбудителем токсокароза.
Гораздо реже это кошачья аскарида Toxocara cati.
В кишечнике животных паразитируют взрослые черви. Самка выделяет яйца, которые с фекалиями животного попадают в окружающую среду.
Человек проглатывает яйца червя, в которых находятся инвазивные личинки. В кишечнике личинки выходят из яиц и внедряются в слизистую оболочку стенки кишки. Так происходит их попадание в мелкие сосуды, а затем в общий кровоток. Личинки разносятся по всему организму и могут задерживаться в органах, образуя гранулемы, или менять свою локализацию.
Токсокароз у человека – это эпидемиологический тупик для паразита. Со временем личинки либо погибают, либо мигрируют долгое время из одного места в другое. Но во взрослого червя в теле человека никогда не разовьются.
Вероятность заражения зависит от частоты контакта с животными и соблюдения правил личной гигиены.
Группы риска составляют:
- дети дошкольного возраста;
- ветеринары и работники собачьих питомников;
- рабочие из сферы коммунального хозяйства, продавцы и производители сельскохозяйственной продукции;
- лица с психическими расстройствами;
- дачники, активно работающие на приусадебных участках;
- охотники.
Передается токсокароз фекально-оральным путем, а провоцирующими моментами являются грязные руки, вода из открытых водоемов, плохо промытые овощи и фрукты.
Симптомы и признаки токсокароза
Клинические проявления определяются местом пребывания личинок и развитием организмом аллергической реакции на присутствие паразитарных антигенов.
Особенно сильно проявляются симптомы аллергии в период миграции личинок и при их гибели.
Аллергические проявления часто бывают единственным симптомом, имеющимся у больного.
Они на фоне токсокароза у взрослых и детей могут быть в виде:
- зудящего дерматита;
- часто возникающих отеков Квинке;
- рецидивирующей крапивницы;
- ринита и конъюнктивита;
- сухого кашля и приступов затрудненного дыхания.
По преимущественной локализации поражений выделяют следующие формы токсокароза:
- Висцеральный, при котором поражаются внутренние органы.
- Нервной системы, когда наблюдаются симптомы вовлеченности головного или спинного мозга.
- Отдельно мышц.
- Токсокароз кожи.
- Органа зрения.
- Поражение различных органов и тканей.
- Диссеминированный, распространенный токсокароз.
Поражение личинками собачьей аскариды может протекать скрыто, бессимптомно, а может сопровождаться яркими клиническими проявлениями.
При манифестном висцеральном токсокарозе наиболее часто у больных отмечаются непостоянная лихорадка, увеличение печени и селезенки, наличие периферических плотноватых на ощупь лимфатических узлов.
Примерно у половины поражаются легкие. Отмечаются сухой или влажный кашель, особенно выраженный в ночное время, выраженная слабость и потливость. Бывают затрудненное дыхание, одышка при физической нагрузке. Над поверхностью легких выслушиваются свистящие, или рассеянные, или мелкопузырчатые хрипы.
Со стороны желудочно-кишечного тракта бывают диарея и боли в животе, постоянная тошнота, повторная рвота, вздутие кишечника.
В случае поражения нервной системы появляются характерные симптомы:
- парезы и параличи;
- судорожные припадки;
- очаговые расстройства;
- менингеальные проявления;
- нарушение двигательной активности;
- расстройства речи
- головные боли;
- нарушения сна.
При мышечной форме возникают не связанные с физическими нагрузками боли в мышцах.
Если развивается кожная форма, то на разных участках кожи появляются пятнисто-папулезные или пузырьковые высыпания. Иногда элементы похожи на разной степени выраженности акне.
Глазной токсокароз обычно наблюдается в одном глазу. При этом выявляются проявления воспалительного характера разных сред глаза. У детей возможно косоглазие. В результате поражения органа зрения снижается острота зрения, а при поражении зрительного нерва даже может возникнуть слепота.
Как одно из проявлений сенсибилизации организма и аутоиммунных нарушений развиваются воспалительные поражения суставов и сосудов.
Артрит или васкулит часто сопровождают любые формы токсокароза.
Не редкость – бессимптомное течение болезни, выявляемое только по результатам анализа крови на специфические антитела.
Также выделяют инаппарантную или субклиническую форму, при которой больных беспокоят боли в животе, слабость, головная боль, кашель, может отмечаться лихорадка.
Диагностика токсокароза
Единственным анализом на токсокароз, подтверждающим наличие личинки, является ИФА (иммуноферментный анализ) на определение специфических антител класса G. Для исследования используется сыворотка крови.
Антитела появляются уже через 6 недель после инфицирования и сохраняются длительное время. Количество антител указывает на активность заболевания и тяжесть процесса.
Ложноположительные результаты могут быть при аутоиммунных заболеваниях, аллергических реакциях или других гельминтозах. Ложноотрицательные бывают при глазной форме из-за небольшого количества в крови антигена.
Положительным считается результат, при котором титр составляет 1:800 и более. Титры менее этого значения могут свидетельствовать лишь о контакте с паразитом.
Проводить исследование необходимо:
- если имеются нарушения в работе внутренних органов на фоне повышения количества эозинофилов в крови;
- когда внезапно нарушается зрение на один глаз;
- при часто повторяющихся аллергических реакциях;
- по эпидемиологическим показаниям, если есть риск заражения и возможен контакт с инфицированными животными.
В диагностическом плане важны результаты общего анализа крови, в которых повышается количество эозинофилов.
Лечение токсокароза
Препараты при токсокарозе назначаются в соответствии с клиническими рекомендациями. Терапия проводится противопаразитарными средствами, в основном албендазолом или мебендазолом.
Длительность курса зависит от тяжести течения и формы заболевания. Курсы повторяют не ранее, чем через три месяца. Для полного излечения иногда требуется не менее 4-х курсов.
Помимо противопаразитарного лекарства при токсокорозе обязательно назначают антигистаминные и симптоматические средства.
Прогноз чаще всего благоприятный, но при попадании личинок в жизненно важные органы может быть довольно серьезным.
Профилактика токсокароза
Для того чтобы не дать возможности попасть личинкам в желудочно-кишечный тракт человека, необходимо соблюдать элементарные правила гигиены:
- не надо забывать мыть руки после контакта с животными, перед приемом пищи;
- следует регулярно проводить дегельминтизацию домашних питомцев;
- нельзя допускать кошек и собак на детские площадки и в песочницы;
- стоит внимательно следить за малолетними детьми во время прогулок, чтобы они не брали в рот землю и песок.




